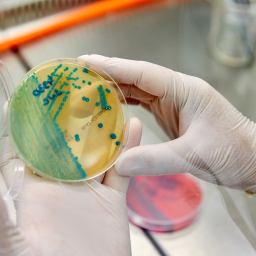

NOTICIA
Innovaciones en el cultivo de lúpulo en España para mejorar la sostenibilidad de las explotaciones agrícolas
18 agosto 2020
Innovaciones en el cultivo de lúpulo en España para mejorar la sostenibilidad de las explotaciones agrícolas
El Grupo Operativo Supraautonómico Lúpulos de calidad presenta las líneas de trabajo de su actual proyecto de Innovación
Los miembros del Grupo Operativo Lúpulos de Calidad, que aglutinan a 8 equipos de trabajo de 3 comunidades autónomas presentan su proyecto sobre Innovaciones en el cultivo de lúpulo en España para mejorar la sostenibilidad de las explotaciones agrícolas. El encuentro se celebrará en la modalidad On Line el próximo día 19 de Agosto a partir de las 10 de la mañana.
El próximo 19 de Agosto se celebrará un evento On Line en el que participarán representantes de las instituciones y entidades de Castilla y León, Galicia y el País Vasco que forman parte del Grupo Operativo Lúpulos de Calidad, asi como el resto de colaboradores de otras regiones. El objetivo de esta reunión es dar a conocer los últimos avances del proyecto sobre Innovaciones en el cultivo de lúpulo en España para mejorar la sostenibilidad de las explotaciones agrícolas.
Este proyecto, financiado por el Fondo Europeo Agrícola de Desarrollo Rural, está destinado a mejorar la competitividad de las explotaciones españolas de lúpulo a través del manejo sostenible del cultivo. Los principales objetivos del proyecto giran en torno a temas como el control sostenible de plagas y enfermedades, la optimización de los sistemas de riego y fertilización, así como en la sostenibilidad medioambiental y económica de las explotaciones.
Para participar en el evento es necesario inscribirse previamente:
Grupo Operativo Lúpulos de Calidad
El grupo operativo se crea en 2018 con el objetivo de fomentar las innovaciones y la valorización del cultivo de lúpulo en España. Se partió para ello de las principales zonas cultivadoras de lúpulo en la actualidad: Castilla y León, Galicia y País Vasco. Los miembros y colaboradores del grupo operativo desarrollan su actividad en estas zonas y representan diferentes segmentos de la cadena de valor del sector.
El grupo operativo está formado por diferentes entidades que representan a cultivadores, productores y comercializadores como SAT LÚPULOS DE LEON, COOPERATIVA LUTEGA Y HOPSTEINER ESPAÑA. Universidades como UNIVERSIDAD DE LEÓN y UNIVERSIDAD DE SANTIAGO, concretamente en el CAMPUS TERRA. Centros de Investigación como la AGENCIA GALEGA DA CALIDADE ALIMENTARIA (AGACAL), el Instituto Tecnológico Agrario de Castilla y León (ITACyL), y el Instituto Vasco de Investigación y Desarrollo Agrario (NEIKER).
El Grupo Operativo cuenta además con la colaboración de Cerveceros de España y las Asociaciones Poeda (León) y Mariñas-Betanzos (Galicia)
Todos los miembros tienen experiencia dentro de sus respectivas actividades en el cultivo del lúpulo. La composición de este Grupo Operativo garantiza por tanto el intercambio de conocimiento entre los agricultores, centros de asesoramiento, empresa y sector de la investigación.